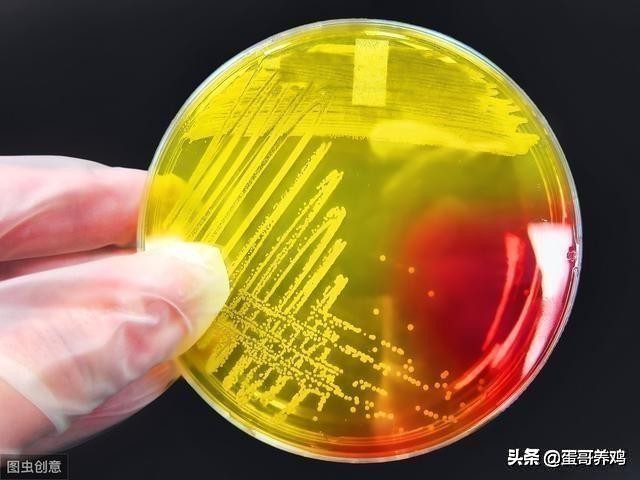
养鸡专用病毒及防治,养鸡如何防鸡瘟

蛋哥宗旨:用质朴的语言,帮助养鸡朋友们,提升养鸡高产技术,解决实质性难题!
蛋鸡养殖中,鸡舍环境差、病原多,很容易造成鸡群呼吸道病、肠道病反复发生,且不能彻底治愈。很多养鸡户遇到这种问题时,首先考虑的不是疾病反复发生的原因,而是用什么药物有效,忽视了解决鸡舍环境差、病原多才是避免疾病再次发生的关键。通过带鸡消毒,能降低鸡舍内病原菌的浓度,减少鸡群反复发病,是养鸡户必备的基本技能。那么,养鸡户如何科学有效进行带鸡消毒?下面我们来了解下,带鸡消毒要掌握3大技巧。

一、做好带鸡消毒有哪些好处?
1、杀灭鸡舍中的病原菌。鸡舍内存在有大肠杆菌、葡萄球菌、魏氏梭菌、球虫等病原微生物,加上鸡舍环境适宜于病原微生物的生存繁殖,做好带鸡消毒能杀灭鸡舍内的病原菌,减少病原微生物的数量。
2、沉降粉尘,减少鸡呼吸病的发生。鸡舍内悬浮有大量的粉尘颗粒,携带有病原微生物的粉尘很容易通过鸡呼吸道黏膜感染,诱发鸡出现呼吸道问题。做好带鸡消毒,能沉降鸡舍内的粉尘颗粒,减少鸡呼吸道病的发生。
3、净化水线,减少鸡肠道病的发生。鸡舍水线脏、水质差,都有利于水线中病原微生物的繁殖和生物膜的产生,造成水中大肠杆菌、沙门氏菌的超标,导致鸡群肠道问题反复发生。做好水线消毒,可以清理掉内壁的生物膜,降低水线中病原菌的数量,减少肠道问题的发生。
二、带鸡消毒有哪些操作技巧?
1、选择合适的消毒剂
喷雾消毒:选择毒副作用小、杀菌力好的消毒剂,如聚维酮碘、季铵盐类(百毒杀、新洁尔灭)、二氧化氯等消毒剂来消毒鸡舍环境;水线消毒:选择双氧水、过氧乙酸、次氯酸盐来消毒水线。
2、掌握2种带鸡消毒的操作技巧---喷雾消毒和饮水消毒
(1)喷雾消毒:先打扫+再喷雾
a、先彻底打扫。消毒前要先对舍进行打扫,将鸡舍的杂物、鸡粪、蜘蛛网、羽毛等彻底清除掉并清理干净,避免潜藏在污物里面细菌病毒没有释放出来,影响消毒效果。

b、再喷雾消毒。交替轮换使用聚维酮碘、百毒杀、二氧化氯等消毒剂,从由里向外、由后往前、从上往下,逐层对鸡舍空气、笼具、墙壁、地面等进行消毒。消毒液呈雾状均匀落在整个支撑系统、墙面、地面,消毒时间至少30分钟。

(2)水线消毒:先浸泡+再反冲+查乳头
a、先浸泡。晚上鸡舍熄灯前,在水线中添加双氧水、过氧乙酸、次氯酸盐等消毒剂,整晚浸泡饮水管道。
b、再反冲。早上天亮前,反向冲洗饮水管道,把水线内的污水排出,最后用高压水泵冲洗水线,利用水压冲洗水线内壁的“生物膜”或用毛刷来清洗水线内壁的污浊物。
c、最后检查。冲洗干净后,检查饮水乳头是否通畅,避免被堵塞。

3、把握好带鸡消毒的时间和频次
a、喷雾消毒。交替轮换使用不同类型的消毒剂,冬季建议在午后温度较高时带鸡消毒,每2天1次;夏季建议在早上凉爽的时候带鸡消毒,每1-2天1次,可有效减少环境中的病原菌。对于存在流行病的鸡场,发病期间坚持每天进行带鸡消毒,以减少病原的扩散和传播。
b、水线消毒。根据水质和水线的污浊情况,冬季每2-3周做一次水线消毒,夏季每1-2周,做一次水线消毒,降低水线中病原微生物对鸡群的危害,减少肠道病的发生。

三、带鸡消毒要注意哪些问题?
1、养殖场至少要备有3种以上的消毒剂,定期交替轮换使用,杀灭芽孢、病毒、细菌等不同类型的病原,避免产生耐药性。
2、喷雾消毒前一定要先打扫,把鸡舍的杂物、鸡粪、蜘蛛网、羽毛等彻底清除掉并清理干净,才能更彻底杀灭鸡舍内的病原微生物。
3、喷雾消毒时间不能少于30分钟,消毒药物要现用现配,防止氧化或日照失效。
4、冬季建议在午后进行喷雾消毒,夏季建议在早晨进行喷雾消毒,避免因喷雾造成鸡群冷热应激。
5、带鸡消毒前后24小时内不能进行活苗免疫及益生菌相关产品的使用,避免影响疫苗和有益菌的活性。

农村 蛋鸡 养殖
以上就是鸡舍带鸡消毒的技巧及需要注意的事项,希望养鸡朋友能重视带鸡消毒,做好喷雾和水线消毒,减少疾病的反复发生。
蛋哥宗旨:用最质朴的语言,帮助蛋鸡养殖户分享经验,高产技术,解决实质性难题。
点击下面蓝色的“了解更多”,看历史技术好文章~